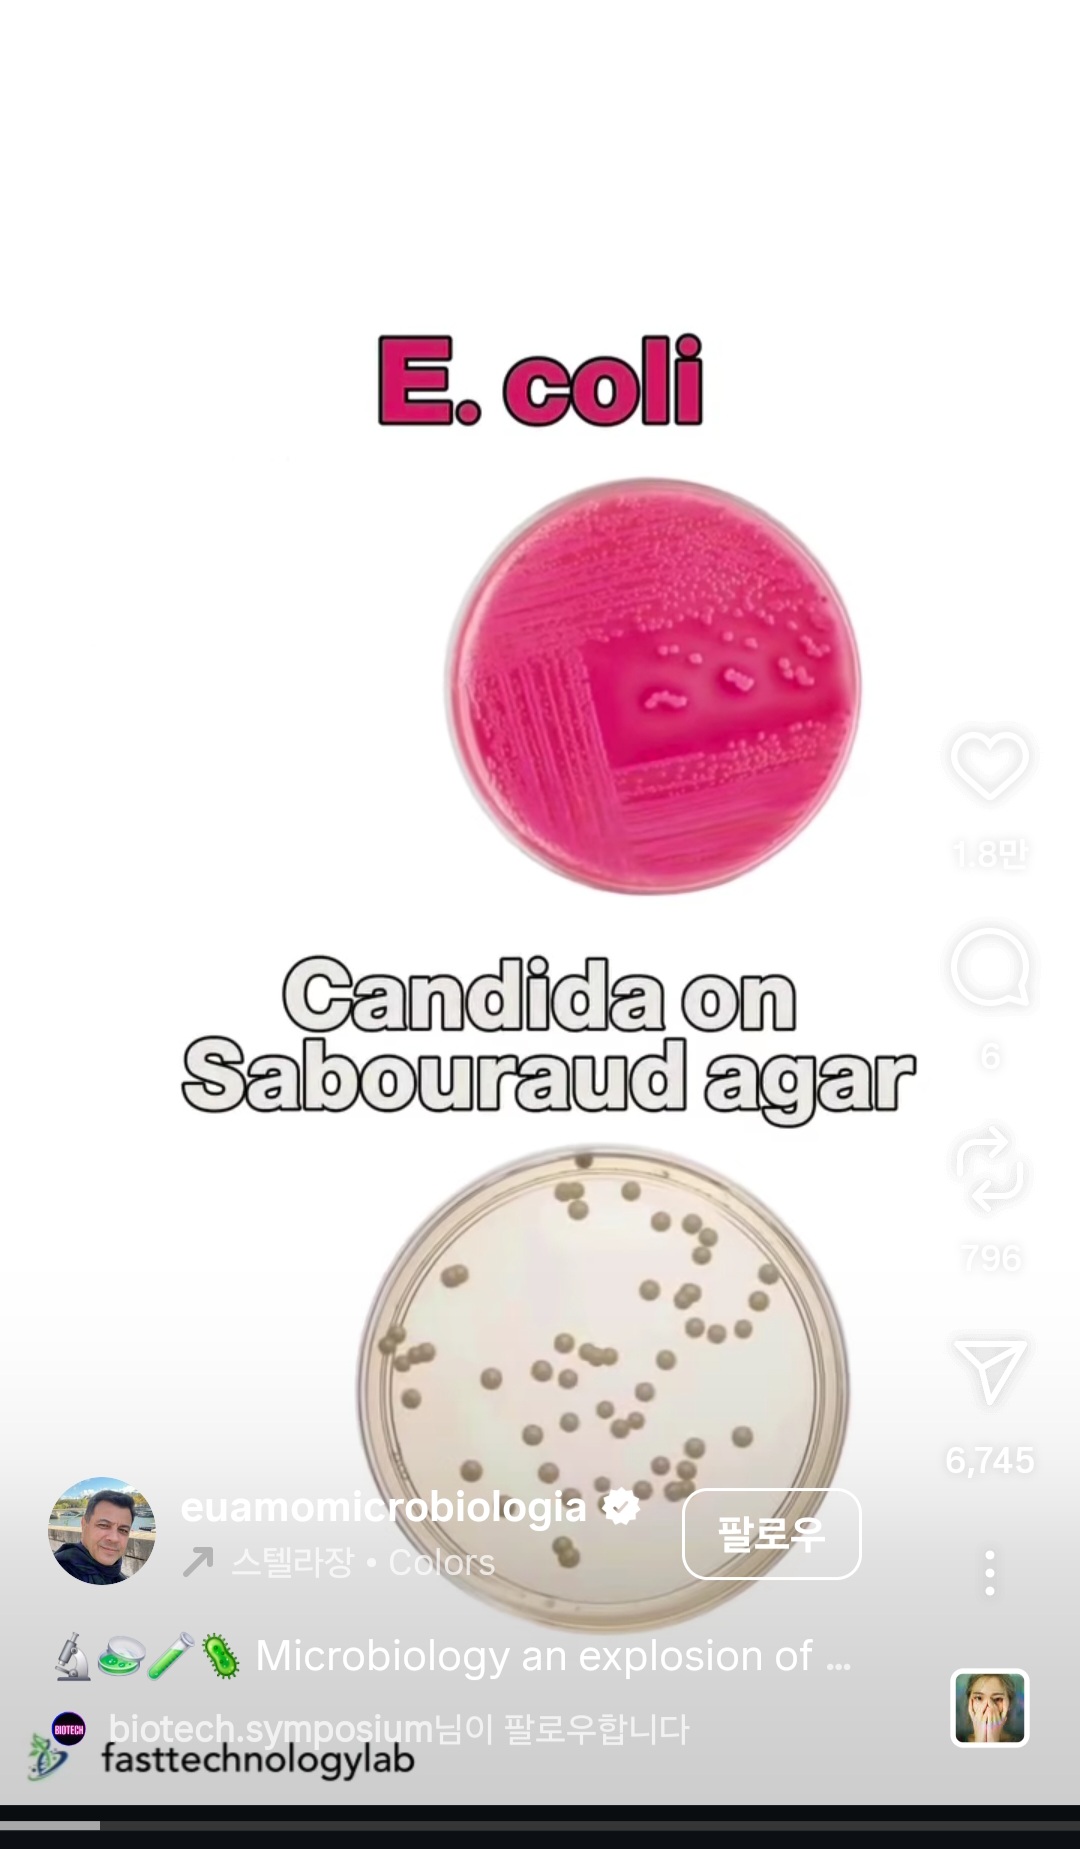

2025-11-16 15:26:22
ⓞ 추천
ⓤ 단축URL
|
|
|




|




|
이상한 사람들 진짜 많고 재밌음
2025-11-16 15:26:22
ⓞ 추천
ⓤ 단축URL
|
|
|




|

|
이상한 사람들 진짜 많고 재밌음
|
|